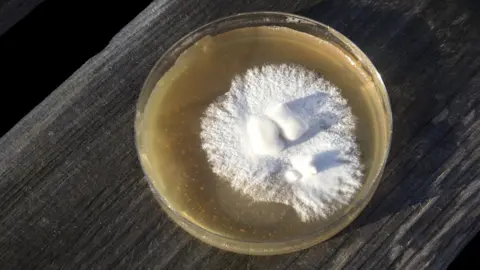
Alicia Canter Mycelium growing in a petri dish

The mushrooms you can wear and build with
[ad_1]
Alicia Canter
Alicia CanterThere’s no doubt mushrooms are having a moment.
From the popular Netflix documentary Fantastic Fungi, to the surge of medical trials exploring the use of a compound found in hallucinogenic species as a treatment for depression, a mushroom boom is alive and kicking.
But there’s one part of fungi that businesses are now especially tapping into, and that’s mycelium, the root structure of a mushroom.
London-based biomanufacturing company Biohm grows mycelium on a large scale by feeding it the likes of food waste and sawdust to create construction industry products such as insulation panels. These can then be used as an alternative to the prevalent plastic ones.
“We are focused on solving global challenges, and one of the largest in terms of impact on the planet and ecosystem is the construction industry,” explains Oksana Bondar, director of design at Biohm.
“We looked deeper into waste streams, and types of materials, and the fabric of buildings, and one of the largest commodities is insulation. The idea was to tackle one of the challenges with a natural solution.”
Once the mycelium has grown over a number of weeks, Biohm harvests and dries it, and then compresses it into brick-like panels.
“What’s beautiful about this product is that the panels can be remanufactured, it can be broken down into feed stock, it’s safe to be composted, it’s pH neutral and 100% natural. It can fertilise soil,” says Ms Bondar.
A spokeswoman for Biohm said the company was “currently negotiating… with major multinationals” to take its products to global markets. “Expect to see their mycelium thermal insulation being installed in homes, offices, and public spaces in the UK and Europe within the next couple of years.”
 Biohm
BiohmIn San Francisco, a company called MycoWorks is growing mycelium to produce a leather substitute called “Reishi”. Using this material it is now making everything from hats to wallets, handbags and bowls.
“Mycelium-grown Reishi is an incredible material, and the first of its kind [leather replacement] that doesn’t use plastic as a core ingredient,” says Sophia Wang, MycoWorks co-founder.
“It is grown using three organic materials – water, sawdust and mycelium, which keeps carbon emissions low.”
She adds that the luxury goods sector is currently showing the most interest in the company’s work. MycoWorks has already helped Hermes produce a handbag partly made from its mycelium, and it has formed a collaboration with hat-maker Nick Fouquet.
MycoWorks is also working with General Motors to explore the use of mycelium in car interiors.
Ms Wang says the firm “coaxes” mycelium to grow into a large brick. The top layer of this, which is said to look like a sheet of animal leather, is then peeled off and can be tanned or coloured in the same way as leather.
Ms Wang says the cost of Reishi is currently comparable to luxury leather. However, she hopes that as the firm introduces production on a much larger scale, the price will fall.
To achieve this growth the company has raised $125m (£104m) to fund the building of a new facility that will allow it to ramp up output from thousands of sheets a year to millions. This is due to open in South Carolina later this year.
 MycoWorks
MycoWorksWhile it’s difficult to source figures for the financial value of the mycelium sector, its rapid growth is undoubtedly increasing that of the wider global mushroom market. This is due to reach $90.4bn by 2028, up from $63bn in 2022, according to research company Imarc Group.
“I think the reason for the expanded interest in mycelium for materials science applications is just increased awareness,” says Dr Mitchell Jones, a researcher at the Vienna University of Technology, and an expert on mycelium.
“When I started my PhD on the topic about seven years ago nobody knew about it. There was almost no documented research on mycelium-based materials and just two companies in the US doing stuff with it.
“These days the topic is much more popular. Companies are popping up everywhere including the US, UK, Italy, the Netherlands, Indonesia, South Korea, Estonia and Australia. The more media attention the topic gets the more people want to get into it commercially and found start-ups. The allure is the ‘weirdness’ of the concept, for want of a better term.”


New Tech Economy is a series exploring how technological innovation is set to shape the new emerging economic landscape.

For Dr Jones, mycelium’s strong sustainable kudos makes it an attractive material. For starters, it is usually made using agricultural or forestry by-products, or food waste that would otherwise have been incinerated or gone into landfill.
He adds that unlike most manufacturing processes – which may use a lot of energy and require machinery – fungi, a biological organism, basically does the hard work for you, simply by growing.
But are there any downsides to the use of mycelium? Dr Jones cautions that it has to be effectively sealed with water repellent, “because if you don’t it is like a sponge compared to other materials, it is susceptible to sucking up large quantities of water”.
And he adds that we don’t yet know how long it will last for. “As it hasn’t yet been produced on a commercial scale we don’t have accurate life assessment data.”
 Bosque Foods
Bosque FoodsBerlin-based Bosque Foods has raised $3m to develop mycelium-based substitutes for chicken, pork and bacon.
Isabella Iglesias-Musachio, its co-founder and chief executive, says they grow their mycelium “in a matter of days” in fermentation vessels that allow for indoor, urban farming.
“From our perspective this is advantageous because we are able to scale up our production in a much more cost-effective way, which means we can reach price parity with animal meat sooner,” she says.
Bosque’s mycelium is said to have a mild flavour, with a hint of “umami” or savoury notes. To this it adds a range of spices.
The situation in the UK has been complicated by Brexit, but the UK’s Food Standards Agency has maintained EU authorisation rules for so-called “novel foods”. These are food substances that were not consumed “significantly” prior to 1997.
Ms Iglesias-Musachio is adamant that mycelium is the future of vegan food. “Some of the issues with plant-based alternatives is that soy and pea protein isolates can have a very strong flavour which on its own many people find off-putting.
“Our mycelium can act as a blank canvas for us to create delicious flavour profiles that people crave.”
[ad_2]
Source link





